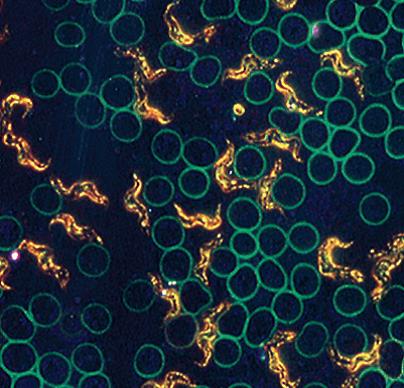

联系人:吴经理
邮箱:211087793@qq.com
电话:13801740727
地址: 中国 上海 浦东新区上海市浦东新区惠南镇惠东路665号
Axio Lab.A1
经认证的人体工程学设计、经济实用、性能优。
蔡司临床级正置显微镜Axio Lab.A1经TüV认证的人体工程学设计可提供操作舒适度。
选择合适的ergotube和ergophototube镜筒:以观察角度评估染色组织切片、血涂片或免疫学样品。只需一只手便能完成主要部件的控制,包括载物台调节、微调对焦和亮度调节。

在实验室工作时,可靠的显微图像是必不可少的特别。Axio Lab.A1你可以放心,您的显微镜工作成本效益和性能高。对于长期使用者的独特优势:人体工程学设计。
蔡司显微镜Axio Lab.A1适用于日常实验室工作需要。在明场,暗场,相衬和荧光所有应用程序可以容易地进行,用蔡司IC2S透镜的整个范围。
一目了然决定性的优势:
· TüV 认证的人体工程学设计,提供舒适度和轻松的工作条件
· 所有控制装置按照人体工程学排列,且使用软触摸材料制成
· 在细胞学和免疫荧光应用中提供具有出色光学质量的可靠结果
· 支持明场、相差、偏光和暗场技术
· 用于培训和团队协同工作的多人共览系统
· 可选配 35 W 卤素灯、日光型 LED 或暖光型 LED 的透射光光源
· 可选配长效 LED 的内置式荧光光源

个实验室显微镜测试人机工程学
Axio Lab.A1的人体工程学和安全处理是由许多吸引人的特征保证。
TUV认证的人体工学设计
蔡司正置显微镜Axio Lab A1特别强调人体工学特征,因为持续的显微镜使用会让人觉得不舒服,特别是脖子。Axio Lab A1用户能够以合适的方式观察玻片,并保持脖子和肩膀肌肉放松。显微镜高度持续可调50mm,另外,观察筒可以从8-33度持续可调。


IC2S光学
无限远色差校正系统,是Zeiss的专利。此系统保证了明亮的色差校正和高度对比的结果,满足对于成像的所有要求。
耐用性
显微镜使用时间越长,在质量上的投资就越值得。Axio Lab A1保值又有长寿命。

易用性:与撑着胳膊工作;所有的主要控制都用一只手进行操作。
新的多人共览系统
来自蔡司的多人共览也是与蔡司显微镜AxioLabA1兼容的。对于所有的观察者都可以看到同样的相片。
皮肤友好型材料增加了舒适性
很多部件被涂覆了摸起来很软的材料,这些材料和金属相比性能优良,不那么冷并且更高的摩擦力。
模块化照明
方便并且易于更换灯泡,创新地使用了暖光型LED提供了长寿命,节能和类似卤素灯颜色效果。
综合工具储藏和导线支持
在后面,例如用来调节相差环中心的工具永远放在那里不会丢失。

Axio Lab.A1的功能:
许多应用
Axio Lab.A1不同临床应用是容易且有效可行的。
蔡司显微镜Axio Lab A1适用于多个领域。微生物学,细胞学,血液学和病原学实验室以及那些学校和大学将会受益于此。

血液学:明场,疟原虫,
实验室中的荧光显微镜
易于使用的LED荧光带有2个LED和来自Carl Zeiss的标准的“推-滴答”模块,与标准的HBO照明相比,LED照明更安全,更节能,更快更易于使用。另外,不需要预热和冷却,并且不需要改变或更换灯泡。

FITC染色后的小鼠肾脏
荧光染料FITC主要用于在免疫学的抗原抗体反应。FITC结合的抗体分子,并在由470nm的LED的强烈绿色荧光激发发射。
明场和暗场显微镜
显微镜主要的操作部件,例如载物台,细准焦螺旋和光强都可以通过一只手来完成,解放了另外一只手。这在明场血影检测中特别有用。暗场血液分析对于早期诊断疾病是非常有用的,因为精细和未染色的结构在明场背景下是很难看到,主要应用于血液学和皮肤病学。
血液学:血涂片,暗场
蔡司显微镜Axio Lab A1提供5位的阿贝聚光镜,带有暗场和相差1,2,3
偏光相差用于检测晶体的双折射,在医学上用来检测痛风或石棉

痛风研究:尿酸结晶,偏光
| 型号
|
Axio Lab.A1
|
|
光学系统
|
IC2S
|
|
操作方式
|
手动
|
|
观察方式
|
透射光、暗场、LED荧光、相差、透射偏光
|
|
透射光装置
|
包含在主机内(卤素或LED照明)
|
|
荧光转盘
|
4孔位荧光
|
|
物镜转盘
|
5孔位
|
|
物镜
|
4X-100X
|
|
目镜
|
10倍或16倍,视野数16或20或22
|
|
载物台
|
机械载物台
|
|
光源
|
35W卤素灯或LED暖光型或LED日光型,LED荧光激发
|